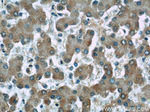
Alpha galactosidase A Antibody in Immunohistochemistry (Paraffin) (IHC (P))

Search
Proteintech
Alpha galactosidase A Monoclonal Antibody (2B2C5)
{{$productOrderCtrl.translations['antibody.pdp.commerceCard.promotion.promotions']}}
{{$productOrderCtrl.translations['antibody.pdp.commerceCard.promotion.viewpromo']}}
{{$productOrderCtrl.translations['antibody.pdp.commerceCard.promotion.promocode']}}: {{promo.promoCode}} {{promo.promoTitle}} {{promo.promoDescription}}. {{$productOrderCtrl.translations['antibody.pdp.commerceCard.promotion.learnmore']}}
产品信息
66121-1-IG
种属反应
宿主/亚型
分类
类型
克隆号
抗原
偶联物
形式
浓度
规格
纯化类型
保存液
内含物
保存条件
运输条件
产品详细信息
Immunogen sequence: WKDAGYEYL CIDDCWMAPQ RDSEGRLQAD PQRFPHGIRQ LANYVHSKGL KLGIYADVGN KTCAGFPGSF GYYDIDAQTF ADWGVDLLKF DGCYCDSLEN LADGYKHMSL ALNRTGRSIV YSCEWPLYMW PFQKPNYTEI RQYCNHWRNF ADIDDSWKSI KSILDWTSFN QERIVDVAGP GGWNDPDMLV IGNFGLSWNQ QVTQMALWAI MAAPLFMSND LRHISPQAKA LLQDKDVIAI NQDPLGKQGY QLRQGDNFEV WERPLSGLAW AVAMINRQEI GGPRSYTIAV ASLGKGVACN PACFITQLLP VKRKLGFYEW TSRLRSHINP TGTVLLQLEN TMQMSL (81-425 aa encoded by BC002689)
靶标信息
This gene encodes a homodimeric glycoprotein that hydrolyses the terminal alpha-galactosyl moieties from glycolipids and glycoproteins. This enzyme predominantly hydrolyzes ceramide trihexoside, and it can catalyze the hydrolysis of melibiose into galactose and glucose. A variety of mutations in this gene affect the synthesis, processing, and stability of this enzyme, which causes Fabry disease, a rare lysosomal storage disorder that results from a failure to catabolize alpha-D-galactosyl glycolipid moieties.
仅用于科研。不用于诊断过程。未经明确授权不得转售。
生物信息学
蛋白别名: agalsidase alfa; Alpha-D-galactosidase A; Alpha-D-galactoside galactohydrolase; alpha-D-galactoside galactohydrolase 1; alpha-gal A; Alpha-galactosidase A; Galactosylgalactosylglucosylceramidase GLA; Melibiase; unnamed protein product
基因别名: GALA; GLA
UniProt ID: (Human) P06280
Entrez Gene ID: (Human) 2717